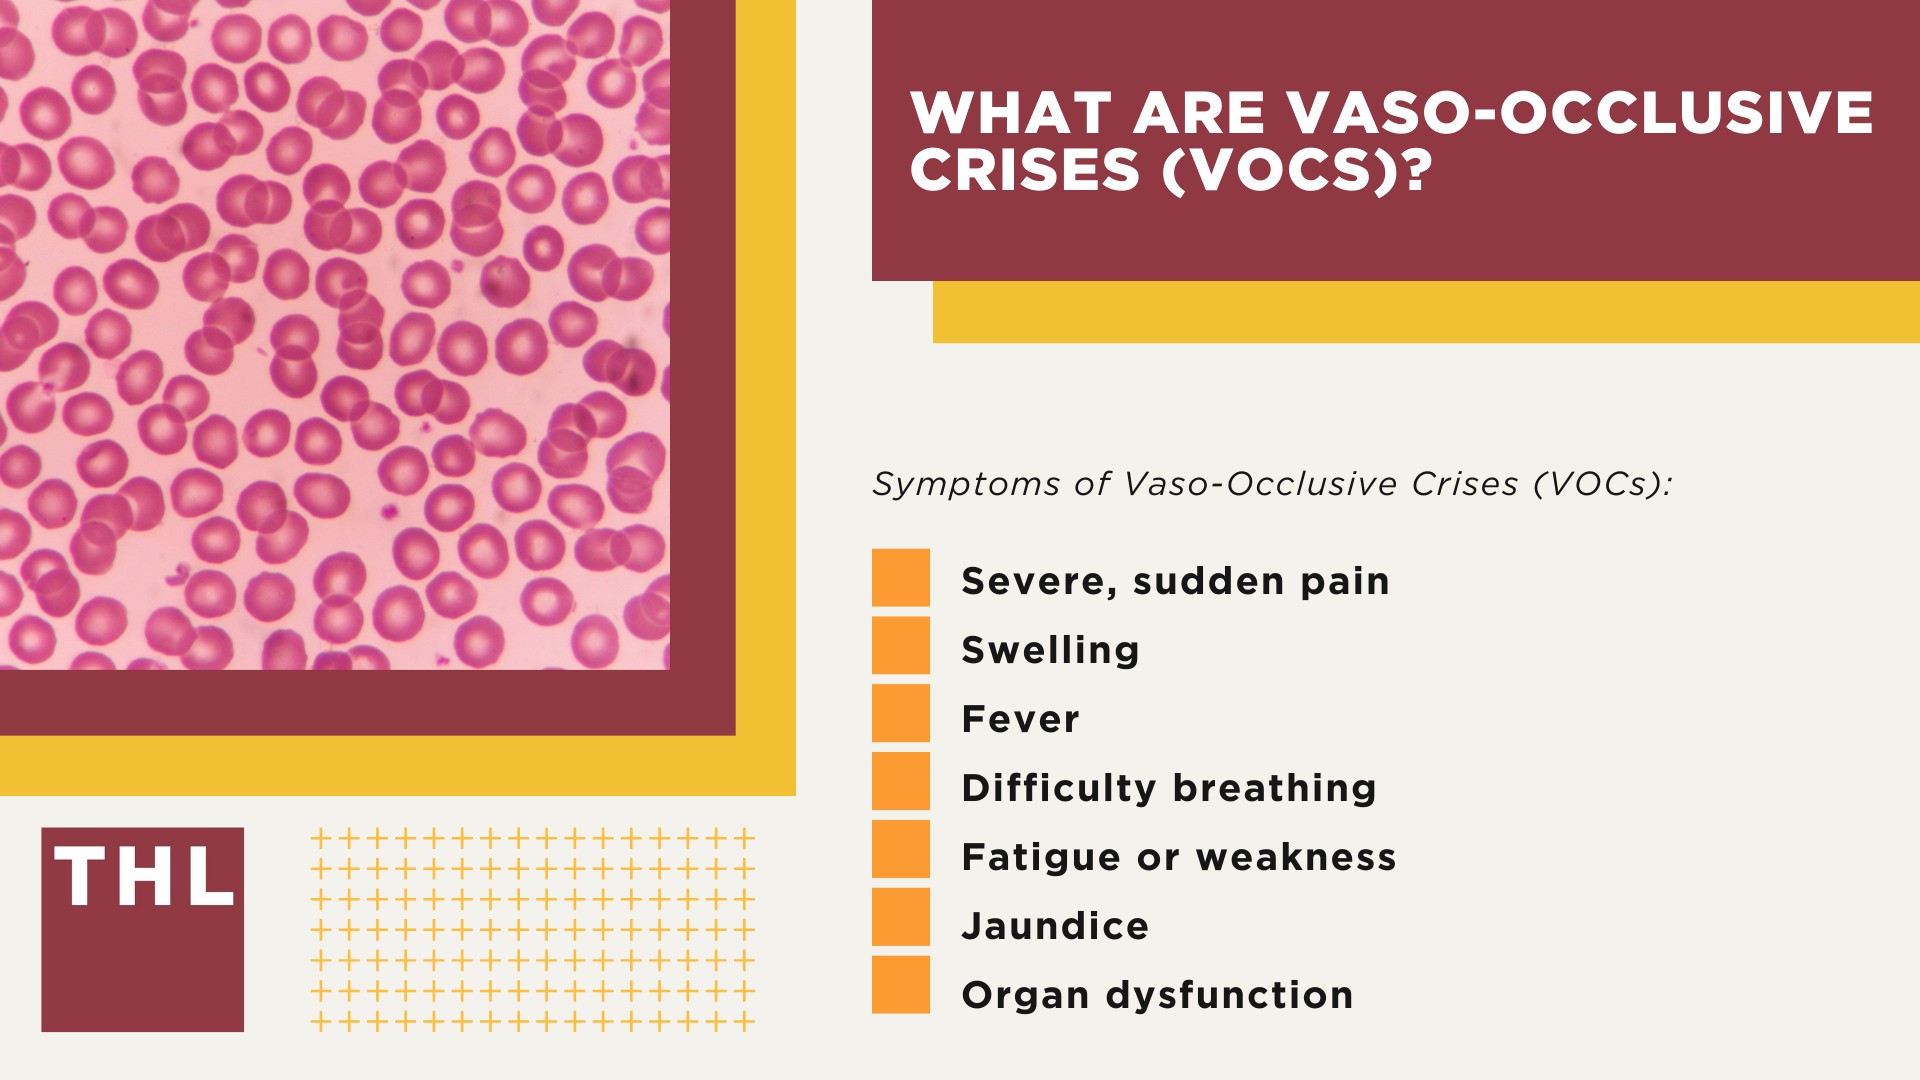
Settlement Projections for Oxbryta Lawsuits; Overview of the Oxbryta Lawsuit Investigation; Oxbryta Recall_ Serious Health Risks Linked to Sickle Cell Disease Treatment; What are Vaso-Occlusive Crises (VOCs)

If you or a loved one suffered injuries, property damage, or other financial losses due to another party’s actions, you may be entitled to compensation for those losses.
Contact the experienced Chicago personal injury lawyers from TorHoerman Law for a free, no-obligation Chicago personal injury lawsuit case consultation today.
If you or a loved one suffered a personal injury or financial loss due to a car accident in Chicago, IL – you may be entitled to compensation for those damages.
Contact an experienced Chicago auto accident lawyer from TorHoerman Law today to see how our firm can serve you!
If you or a loved one have suffered injuries, property damage, or other financial losses due to a truck accident in Chicago, IL – you may qualify to take legal action to gain compensation for those injuries and losses.
Contact TorHoerman Law today for a free, no-obligation consultation with our Chicago truck accident lawyers!
If you or a loved one suffered an injury in a motorcycle accident in Chicago or the greater Chicagoland area – you may be eligible to file a Chicago motorcycle accident lawsuit.
Contact an experienced Chicago motorcycle accident lawyer at TorHoerman Law today to find out how we can help.
If you have been involved in a bicycle accident in Chicago at no fault of your own and you suffered injuries as a result, you may qualify to file a Chicago bike accident lawsuit.
Contact a Chicago bike accident lawyer from TorHoerman Law to discuss your legal options today!
Chicago is one of the nation’s largest construction centers.
Thousands of men and women work on sites across the city and metropolitan area on tasks ranging from skilled trades to administrative operations.
Unfortunately, construction site accidents are fairly common.
Contact TorHoerman Law to discuss your legal options with an experienced Chicago construction accident lawyer, free of charge and no obligation required.
Nursing homes and nursing facilities should provide a safe, supportive environment for senior citizens, with qualified staff, nurses, and aids administering quality care.
Unfortunately, nursing home abuse and neglect can occur, leaving residents at risk and vulnerable.
Contact an experienced Chicago nursing home abuse lawyer from TorHoerman Law today for a free consultation to discuss your legal options.
If you are a resident of Chicago, or the greater Chicagoland area, and you have a loved one who suffered a fatal injury due to another party’s negligence or malpractice – you may qualify to file a wrongful death lawsuit on your loved one’s behalf.
Contact a Chicago wrongful death lawyer from TorHoerman Law to discuss your legal options today!
If you have suffered a slip and fall injury in Chicago you may be eligible for compensation through legal action.
Contact a Chicago slip and fall lawyer at TorHoerman Law today!
TorHoerman Law offers free, no-obligation case consultations for all potential clients.
When a child is injured at a daycare center, parents are left wondering who can be held liable, who to contact for legal help, and how a lawsuit may pan out for them.
If your child has suffered an injury at a daycare facility, you may be eligible to file a daycare injury lawsuit.
Contact a Chicago daycare injury lawyer from TorHoerman Law today for a free consultation to discuss your case and potential legal action!
If you or a loved one suffered injuries, property damage, or other financial losses due to another party’s actions, you may be entitled to compensation for those losses.
Contact the experienced Edwardsville personal injury lawyers from TorHoerman Law for a free, no-obligation Edwardsville personal injury lawsuit case consultation today.
If you or a loved one suffered a personal injury or financial loss due to a car accident in Edwardsville, IL – you may be entitled to compensation for those damages.
Contact an experienced Edwardsville car accident lawyer from TorHoerman Law today to see how our firm can serve you!
If you or a loved one have suffered injuries, property damage, or other financial losses due to a truck accident in Edwardsville, IL – you may qualify to take legal action to gain compensation for those injuries and losses.
Contact TorHoerman Law today for a free, no-obligation consultation with our Edwardsville truck accident lawyers!
If you or a loved one suffered an injury in a motorcycle accident in Edwardsville – you may be eligible to file an Edwardsville motorcycle accident lawsuit.
Contact an experienced Edwardsville motorcycle accident lawyer at TorHoerman Law today to find out how we can help.
If you have been involved in a bicycle accident in Edwardsville at no fault of your own and you suffered injuries as a result, you may qualify to file an Edwardsville bike accident lawsuit.
Contact an Edwardsville bicycle accident lawyer from TorHoerman Law to discuss your legal options today!
Nursing homes and nursing facilities should provide a safe, supportive environment for senior citizens, with qualified staff, nurses, and aids administering quality care.
Unfortunately, nursing home abuse and neglect can occur, leaving residents at risk and vulnerable.
Contact an experienced Edwardsville nursing home abuse attorney from TorHoerman Law today for a free consultation to discuss your legal options.
If you are a resident of Edwardsville and you have a loved one who suffered a fatal injury due to another party’s negligence or malpractice – you may qualify to file a wrongful death lawsuit on your loved one’s behalf.
Contact an Edwardsville wrongful death lawyer from TorHoerman Law to discuss your legal options today!
If you have suffered a slip and fall injury in Edwardsville you may be eligible for compensation through legal action.
Contact an Edwardsville slip and fall lawyer at TorHoerman Law today!
TorHoerman Law offers free, no-obligation case consultations for all potential clients.
When a child is injured at a daycare center, parents are left wondering who can be held liable, who to contact for legal help, and how a lawsuit may pan out for them.
If your child has suffered an injury at a daycare facility, you may be eligible to file a daycare injury lawsuit.
Contact an Edwardsville daycare injury lawyer from TorHoerman Law today for a free consultation to discuss your case and potential legal action!
If you or a loved one suffered injuries on someone else’s property in Edwardsville IL, you may be entitled to financial compensation.
If property owners fail to keep their premises safe, and their negligence leads to injuries, property damages or other losses as a result of an accident or incident, a premises liability lawsuit may be possible.
Contact an Edwardsville premises liability lawyer from TorHoerman Law today for a free, no-obligation case consultation.
If you or a loved one suffered injuries, property damage, or other financial losses due to another party’s actions, you may be entitled to compensation for those losses.
Contact the experienced St. Louis personal injury lawyers from TorHoerman Law for a free, no-obligation St. Louis personal injury lawsuit case consultation today.
If you or a loved one suffered a personal injury or financial loss due to a car accident in St. Louis, IL – you may be entitled to compensation for those damages.
Contact an experienced St. Louis car accident lawyer from TorHoerman Law today to see how our firm can serve you!
If you or a loved one have suffered injuries, property damage, or other financial losses due to a truck accident in St. Louis, IL – you may qualify to take legal action to gain compensation for those injuries and losses.
Contact TorHoerman Law today for a free, no-obligation consultation with our St. Louis truck accident lawyers!
If you or a loved one suffered an injury in a motorcycle accident in St. Louis or the greater St. Louis area – you may be eligible to file a St. Louis motorcycle accident lawsuit.
Contact an experienced St. Louis motorcycle accident lawyer at TorHoerman Law today to find out how we can help.
If you have been involved in a bicycle accident in St. Louis at no fault of your own and you suffered injuries as a result, you may qualify to file a St. Louis bike accident lawsuit.
Contact a St. Louis bicycle accident lawyer from TorHoerman Law to discuss your legal options today!
St. Louis is one of the nation’s largest construction centers.
Thousands of men and women work on sites across the city and metropolitan area on tasks ranging from skilled trades to administrative operations.
Unfortunately, construction site accidents are fairly common.
Contact TorHoerman Law to discuss your legal options with an experienced St. Louis construction accident lawyer, free of charge and no obligation required.
Nursing homes and nursing facilities should provide a safe, supportive environment for senior citizens, with qualified staff, nurses, and aids administering quality care.
Unfortunately, nursing home abuse and neglect can occur, leaving residents at risk and vulnerable.
Contact an experienced St. Louis nursing home abuse attorney from TorHoerman Law today for a free consultation to discuss your legal options.
If you are a resident of St. Louis, or the greater St. Louis area, and you have a loved one who suffered a fatal injury due to another party’s negligence or malpractice – you may qualify to file a wrongful death lawsuit on your loved one’s behalf.
Contact a St. Louis wrongful death lawyer from TorHoerman Law to discuss your legal options today!
If you have suffered a slip and fall injury in St. Louis you may be eligible for compensation through legal action.
Contact a St. Louis slip and fall lawyer at TorHoerman Law today!
TorHoerman Law offers free, no-obligation case consultations for all potential clients.
When a child is injured at a daycare center, parents are left wondering who can be held liable, who to contact for legal help, and how a lawsuit may pan out for them.
If your child has suffered an injury at a daycare facility, you may be eligible to file a daycare injury lawsuit.
Contact a St. Louis daycare injury lawyer from TorHoerman Law today for a free consultation to discuss your case and potential legal action!
Depo-Provera, a contraceptive injection, has been linked to an increased risk of developing brain tumors (including glioblastoma and meningioma).
Women who have used Depo-Provera and subsequently been diagnosed with brain tumors are filing lawsuits against Pfizer (the manufacturer), alleging that the company failed to adequately warn about the risks associated with the drug.
Despite the claims, Pfizer maintains that Depo-Provera is safe and effective, citing FDA approval and arguing that the scientific evidence does not support a causal link between the drug and brain tumors.
You may be eligible to file a Depo Provera Lawsuit if you used Depo-Provera and were diagnosed with a brain tumor.
Suboxone, a medication often used to treat opioid use disorder (OUD), has become a vital tool which offers a safer and more controlled approach to managing opioid addiction.
Despite its widespread use, Suboxone has been linked to severe tooth decay and dental injuries.
Suboxone Tooth Decay Lawsuits claim that the companies failed to warn about the risks of tooth decay and other dental injuries associated with Suboxone sublingual films.
Tepezza, approved by the FDA in 2020, is used to treat Thyroid Eye Disease (TED), but some patients have reported hearing issues after its use.
The Tepezza lawsuit claims that Horizon Therapeutics failed to warn patients about the potential risks and side effects of the drug, leading to hearing loss and other problems, such as tinnitus.
You may be eligible to file a Tepezza Lawsuit if you or a loved one took Tepezza and subsequently suffered permanent hearing loss or tinnitus.
Elmiron, a drug prescribed for interstitial cystitis, has been linked to serious eye damage and vision problems in scientific studies.
Thousands of Elmiron Lawsuits have been filed against Janssen Pharmaceuticals, the manufacturer, alleging that the company failed to warn patients about the potential risks.
You may be eligible to file an Elmiron Lawsuit if you or a loved one took Elmiron and subsequently suffered vision loss, blindness, or any other eye injury linked to the prescription drug.
The chemotherapy drug Taxotere, commonly used for breast cancer treatment, has been linked to severe eye injuries, permanent vision loss, and permanent hair loss.
Taxotere Lawsuits are being filed by breast cancer patients and others who have taken the chemotherapy drug and subsequently developed vision problems.
If you or a loved one used Taxotere and subsequently developed vision damage or other related medical problems, you may be eligible to file a Taxotere Lawsuit and seek financial compensation.
Parents and guardians are filing lawsuits against major video game companies (including Epic Games, Activision Blizzard, and Microsoft), alleging that they intentionally designed their games to be addictive — leading to severe mental and physical health issues in minors.
The lawsuits claim that these companies used psychological tactics and manipulative game designs to keep players engaged for extended periods — causing problems such as anxiety, depression, and social withdrawal.
You may be eligible to file a Video Game Addiction Lawsuit if your child has been diagnosed with gaming addiction or has experienced negative effects from excessive gaming.
Thousands of Uber sexual assault claims have been filed by passengers who suffered violence during rides arranged through the platform.
The ongoing Uber sexual assault litigation spans both federal law and California state court, with a consolidated Uber MDL (multi-district litigation) currently pending in the Northern District of California.
Uber sexual assault survivors across the country are coming forward to hold the company accountable for negligence in hiring, screening, and supervising drivers.
If you or a loved one were sexually assaulted, sexually battered, or faced any other form of sexual misconduct from an Uber driver, you may be eligible to file an Uber Sexual Assault Lawsuit.
Although pressure cookers were designed to be safe and easy to use, a number of these devices have been found to have a defect that can lead to excessive buildup of internal pressure.
The excessive pressure may result in an explosion that puts users at risk of serious injuries such as burns, lacerations, an even electrocution.
If your pressure cooker exploded and caused substantial burn injuries or other serious injuries, you may be eligible to file a Pressure Cooker Lawsuit and secure financial compensation for your injuries and damages.
Several studies have found a correlation between heavy social media use and mental health challenges, especially among younger users.
Social media harm lawsuits claim that social media companies are responsible for onsetting or heightening mental health problems, eating disorders, mood disorders, and other negative experiences of teens and children
You may be eligible to file a Social Media Mental Health Lawsuit if you are the parents of a teen, or teens, who attribute their use of social media platforms to their mental health problems.
The Paragard IUD, a non-hormonal birth control device, has been linked to serious complications, including device breakage during removal.
Numerous lawsuits have been filed against Teva Pharmaceuticals, the manufacturer of Paragard, alleging that the company failed to warn about the potential risks.
If you or a loved one used a Paragard IUD and subsequently suffered complications and/or injuries, you may qualify for a Paragard Lawsuit.
Patients with the PowerPort devices may possibly be at a higher risk of serious complications or injury due to a catheter failure, according to lawsuits filed against the manufacturers of the Bard PowerPort Device.
If you or a loved one have been injured by a Bard PowerPort Device, you may be eligible to file a Bard PowerPort Lawsuit and seek financial compensation.
Vaginal Mesh Lawsuits are being filed against manufacturers of transvaginal mesh products for injuries, pain and suffering, and financial costs related to complications and injuries of these medical devices.
Over 100,000 Transvaginal Mesh Lawsuits have been filed on behalf of women injured by vaginal mesh and pelvic mesh products.
If you or a loved one have suffered serious complications or injuries from vaginal mesh, you may be eligible to file a Vaginal Mesh Lawsuit.
Above ground pool accidents have led to lawsuits against manufacturers due to defective restraining belts that pose serious safety risks to children.
These belts, designed to provide structural stability, can inadvertently act as footholds, allowing children to climb into the pool unsupervised, increasing the risk of drownings and injuries.
Parents and guardians are filing lawsuits against pool manufacturers, alleging that the defective design has caused severe injuries and deaths.
If your child was injured or drowned in an above ground pool accident involving a defective restraining belt, you may be eligible to file a lawsuit.
Recent scientific studies have found that the use of chemical hair straightening products, hair relaxers, and other hair products present an increased risk of uterine cancer, endometrial cancer, breast cancer, and other health problems.
Legal action is being taken against manufacturers and producers of these hair products for their failure to properly warn consumers of potential health risks.
You may be eligible to file a Hair Straightener Cancer Lawsuit if you or a loved one used chemical hair straighteners, hair relaxers, or other similar hair products, and subsequently were diagnosed with:
NEC Lawsuit claims allege that certain formulas given to infants in NICU settings increase the risk of necrotizing enterocolitis (NEC) – a severe intestinal condition in premature infants.
Parents and guardians are filing NEC Lawsuits against baby formula manufacturers, alleging that the formulas contain harmful ingredients leading to NEC.
Despite the claims, Abbott and Mead Johnson deny the allegations, arguing that their products are thoroughly researched and dismissing the scientific evidence linking their formulas to NEC, while the FDA issued a warning to Abbott regarding safety concerns of a formula product.
You may be eligible to file a Toxic Baby Formula NEC Lawsuit if your child received baby bovine-based (cow’s milk) baby formula in the maternity ward or NICU of a hospital and was subsequently diagnosed with Necrotizing Enterocolitis (NEC).
Paraquat, a widely-used herbicide, has been linked to Parkinson’s disease, leading to numerous Paraquat Parkinson’s Disease Lawsuits against its manufacturers for failing to warn about the risks of chronic exposure.
Due to its toxicity, the EPA has restricted the use of Paraquat and it is currently banned in over 30 countries.
You may be eligible to file a Paraquat Lawsuit if you or a loved one were exposed to Paraquat and subsequently diagnosed with Parkinson’s Disease or other related health conditions.
Mesothelioma is an aggressive form of cancer primarily caused by exposure to asbestos.
Asbestos trust funds were established in the 1970s to compensate workers harmed by asbestos-containing products.
These funds are designed to pay out claims to those who developed mesothelioma or other asbestos-related diseases due to exposure.
Those exposed to asbestos and diagnosed with mesothelioma may be eligible to file a Mesothelioma Lawsuit.
AFFF (Aqueous Film Forming Foam) is a firefighting foam that has been linked to various health issues, including cancer, due to its PFAS (per- and polyfluoroalkyl substances) content.
Numerous AFFF Lawsuits have been filed against AFFF manufacturers, alleging that they knew about the health risks but failed to warn the public.
AFFF Firefighting Foam lawsuits aim to hold manufacturers accountable for putting peoples’ health at risk.
You may be eligible to file an AFFF Lawsuit if you or a loved one was exposed to firefighting foam and subsequently developed cancer.
PFAS contamination lawsuits are being filed against manufacturers and suppliers of PFAS chemicals, alleging that these substances have contaminated water sources and products, leading to severe health issues.
Plaintiffs claim that prolonged exposure to PFAS through contaminated drinking water and products has caused cancers, thyroid disease, and other health problems.
The lawsuits target companies like 3M, DuPont, and Chemours, accusing them of knowingly contaminating the environment with PFAS and failing to warn about the risks.
If you or a loved one has been exposed to PFAS-contaminated water or products and has developed health issues, you may be eligible to file a PFAS lawsuit.
The Roundup Lawsuit claims that Monsanto’s popular weed killer, Roundup, causes cancer.
Numerous studies have linked the main ingredient, glyphosate, to Non-Hodgkin’s Lymphoma, Leukemia, and other Lymphatic cancers.
Despite this, Monsanto continues to deny these claims.
Victims of Roundup exposure who developed cancer are filing Roundup Lawsuits against Monsanto, seeking compensation for medical expenses, pain, and suffering.
Our firm is about people. That is our motto and that will always be our reality.
We do our best to get to know our clients, understand their situations, and get them the compensation they deserve.
At TorHoerman Law, we believe that if we continue to focus on the people that we represent, and continue to be true to the people that we are – justice will always be served.
Without our team, we would’nt be able to provide our clients with anything close to the level of service they receive when they work with us.
The TorHoerman Law Team commits to the sincere belief that those injured by the misconduct of others, especially large corporate profit mongers, deserve justice for their injuries.
Our team is what has made TorHoerman Law a very special place since 2009.
The Oxbryta Lawsuit may seek compensation for the extensive physical, emotional, and financial impact linked to the drug’s use.
TorHoerman Law is currently investigating potential Oxbryta Lawsuits and is speaking to potential clients about complications suffered due to the use of the drug.
On this page, we’ll discuss the Oxbryta Lawsuit Settlement Projections, complications associated with Oxbryta (voxelotor) tablets, the legal investigation into serious injuries and other complications, how an Oxbryta Lawyer can help you, and much more.
Oxbryta, a sickle cell disease medicine developed by Pfizer and Global Blood Therapeutics, was once viewed as a groundbreaking option for individuals living with sickle cell anemia.
The FDA approved Oxbryta under the accelerated approval pathway to help prevent red blood cells from sickling, improve oxygen delivery, and reduce painful complications.
However, emerging data suggest that the sickle cell drug Oxbryta carried severe adverse effects that outweighed its intended benefits.
Reports linked the medication to serious complications such as increased vaso-occlusive crises, organ damage, blood clots, and, in some cases, fatalities.
These findings ultimately led to Pfizer voluntarily withdrawing the drug from the market in September 2024.
The withdrawal left many Oxbryta users questioning the long-term impact of the medicine on their health and whether they could file an Oxbryta lawsuit to pursue justice.
As Oxbryta litigation gains momentum, attorneys are evaluating claims involving wrongful death, debilitating side effects, and other lasting harm.
While no official Oxbryta settlement amounts have been determined, early estimates (based on similar pharmaceutical cases) suggest potentially significant payouts.
Depending on the trajectory of the litigation and individual circumstances, lawyers estimate that settlements could potentially range from $20,000 to over $500,000.
The new Oxbryta lawsuit could provide compensation for medical bills, lost income, and other damages caused by the drug’s serious risks.
Please be advised that any projected or estimated settlement amounts mentioned on this page are general estimations and are not guaranteed. These figures are based on similar previous litigations, the nature of injuries sustained, and estimated costs of damages. They are meant to provide a general idea of what settlement ranges could look like and should not be taken as definitive expectations for your case.
Every legal case is unique, with its own specific circumstances that can significantly affect the outcome. This information is not legal advice and does not address the specifics of your situation. To obtain a more accurate understanding of the potential value of your case, it is best to consult directly with a qualified attorney who can provide personalized guidance.
If you or a loved one used Oxbryta (voxelotor) tablets and subsequently experienced severe complications—such as vaso-occlusive crises, organ damage, stroke, kidney failure, or other life-threatening injuries—you may be eligible to pursue legal action for compensation.
Contact TorHoerman Law for a free consultation.
Use the chatbot on this page for a free case evaluation and to get in touch with our Oxbryta Lawyers.
Sickle cell patients taking Oxbryta trusted the medication to alleviate their suffering, but many instead experienced severe health complications, including painful vaso-occlusive crises and organ damage.
These unexpected risks have not only worsened their physical health but have also disrupted their quality of life, leaving families to cope with emotional and financial burdens.
As lawsuits are being investigated, affected individuals are seeking accountability for the harm caused and exploring their legal options for compensation.
Contact TorHoerman Law today for a free case evaluation.
While the Oxbryta Lawsuit is still in its early stages, lawyers have provided preliminary estimates for potential settlement amounts based on the severity of harm suffered by affected individuals.
These early-stage figures are rough estimations of case value and are likely to change significantly as the litigation progresses and more information becomes available.
Settlement amounts will depend on the evolving evidence, individual circumstances, and the ultimate outcomes of ongoing investigations.
These estimates reflect the varying degrees of physical, emotional, and financial damages caused by Oxbryta-related complications, such as vaso-occlusive crises, organ damage, and fatalities.
While no Oxbryta lawsuit settlement amounts are guaranteed, current projections suggest potential settlements could range from $20,000 to over $500,000, depending on the severity of harm.
Below is a breakdown of settlement tiers based on the degree of harm suffered by those impacted.

This tier reflects the highest potential Oxbryta lawsuit settlement amounts and is intended for individuals who have suffered the most catastrophic harm due to Oxbryta-related complications.
This includes patients who tragically passed away or experienced life-threatening events, such as severe organ damage, stroke, or multi-system failure.
Families filing wrongful death claims may also be eligible for compensation under this tier to account for funeral expenses, loss of income, and emotional suffering.
Tier 2 settlements apply to individuals who faced significant but non-fatal complications from Oxbryta, such as recurring vaso-occlusive crises (VOCs), hospitalizations, and lasting organ damage.
These individuals may have required prolonged medical care, blood transfusions, or rehabilitation due to the severity of their symptoms.
Compensation in this tier accounts for medical expenses, lost wages, and the physical and emotional toll of living with these complications.
This tier includes patients who experienced less severe but still notable health complications, such as moderate pain, swelling, fatigue, or gastrointestinal issues linked to Oxbryta use.
While these complications may not have been life-threatening, they still impacted patients’ daily lives and required medical attention.
Compensation at this level may address medical costs, short-term disruptions to work, and the overall strain caused by Oxbryta’s side effects.
The Oxbryta Lawsuit investigation focuses on the serious health complications experienced by sickle cell patients who relied on the medication for treatment.
Pfizer’s voluntary recall of Oxbryta in September 2024 followed emerging clinical data that revealed increased risks of vaso-occlusive crises (VOCs), organ damage, and fatalities among patients taking the drug.
These findings raised serious concerns about whether the risks of Oxbryta were fully disclosed to patients and healthcare providers before its release.
Approved through the FDA’s accelerated approval pathway, the medication was intended to address a critical need for sickle cell disease treatments but has now become the subject of intense legal scrutiny.
Lawyers are investigating whether Pfizer overlooked key safety signals during clinical studies or failed to conduct adequate long-term testing before bringing Oxbryta to market.
Families and individuals affected by severe complications are pursuing legal action to seek accountability and compensation for their physical, emotional, and financial damages.

While the legal investigation is still in its preliminary stages, lawyers aim to uncover whether negligence or inadequate warnings contributed to patient harm.
As the litigation develops, sickle cell patients and their families are encouraged to document their experiences and consult with legal professionals to understand their rights and options for pursuing justice.
If you or a loved one used Oxbryta to manage sickle cell disease and subsequently suffered from severe pain, vaso-occlusive crises (VOCs), or other complications, you may be eligible to file an Oxbryta Lawsuit.
Contact TorHoerman Law today for a free consultation.
Use the chat feature on this page to find out if you qualify for the Oxbryta Lawsuit instantly.
Pfizer, the current manufacturer of the sickle cell disease management drug Oxbryta, is the primary company potentially facing lawsuits following the drug’s recall.
Pfizer acquired Global Blood Therapeutics (GBT)—the original developer of Oxbryta—in 2022, inheriting responsibility for the drug’s production, distribution, and safety monitoring.
Legal investigations are examining whether both companies adequately tested Oxbryta, disclosed risks such as vaso-occlusive crises and fatalities, and fulfilled their duty to warn patients and healthcare providers.
Plaintiffs may pursue claims against these companies for negligence, product liability, and failure to warn about the drug’s severe complications.
Oxbryta (voxelotor) is a prescription medication designed to treat sickle cell disease (SCD), a chronic and life-threatening genetic blood disorder.
SCD causes red blood cells to become rigid and sickle-shaped, impairing their ability to carry oxygen and flow freely through blood vessels.
This leads to frequent blockages known as vaso-occlusive crises (VOCs), which result in severe pain, organ damage, and other critical health complications.
Approved through the FDA’s accelerated approval pathway in 2019, Oxbryta was hailed as a breakthrough for sickle cell patients by directly targeting the abnormal hemoglobin responsible for sickling.
By binding to hemoglobin, Oxbryta aimed to prevent red blood cells from losing their disc-shaped flexibility, improving oxygen delivery and reducing anemia symptoms.
However, despite its initial promise, emerging safety data has since raised concerns about its efficacy and risks, leading to its global recall in September 2024.
Oxbryta’s mechanism of action focuses on stabilizing hemoglobin, the essential protein in red blood cells that carries oxygen throughout the body.
In sickle cell disease, hemoglobin becomes defective, causing red blood cells to deform and clump together, restricting blood flow and oxygen delivery.
Oxbryta works by increasing hemoglobin’s affinity for oxygen, theoretically helping red blood cells maintain their disc-shaped structure and improving their ability to circulate effectively.
This process was intended to reduce the frequency of VOCs, alleviate symptoms of hemolytic anemia, and enhance the overall quality of life for patients suffering from SCD.
Initially approved for individuals aged 12 and older, the FDA expanded Oxbryta’s use in 2021 to include children as young as four, underscoring the urgent need for pediatric treatments in sickle cell management.
The drug was often prescribed for patients with chronic anemia who were not responding adequately to other medicines, such as hydroxyurea or regular blood transfusions.
It was also seen as a valuable addition to comprehensive sickle cell treatment plans, which frequently include symptom management, pain relief, and supportive therapies to address related health complications.
While Oxbryta was designed to meet an unmet need, subsequent clinical and real-world data revealed safety concerns—such as worsening VOCs and organ damage—that ultimately outweighed its potential benefits, prompting its recall.
The recall of Oxbryta (voxelotor) was announced in September 2024 after emerging safety data revealed significant health risks for sickle cell disease (SCD) patients using the medication.
Pfizer, the manufacturer, issued a voluntary withdrawal of Oxbryta following postmarketing clinical studies and real-world registry data that showed an increased incidence of vaso-occlusive crises (VOCs)—a painful and potentially life-threatening complication of SCD.
These studies also revealed a concerning rise in fatal outcomes among patients treated with Oxbryta compared to those receiving a placebo, raising alarms about the drug’s overall safety profile.
The FDA reviewed the available data, including reports of organ damage, severe pain, and other adverse events, ultimately concluding that the risks outweighed the drug’s intended benefits.
Initially granted accelerated approval in 2019 to address the urgent treatment needs of SCD patients, Oxbryta’s recall highlights the challenges of balancing expedited drug approvals with long-term safety monitoring.
While Oxbryta was designed to stabilize hemoglobin and reduce red blood cell sickling, its real-world use demonstrated new risks that led to worsening symptoms for many patients.
Pfizer’s decision to pull Oxbryta from the market also halted all clinical trials and expanded access programs globally, further disrupting treatment plans for patients who relied on the medication.
The European Medicines Agency (EMA) similarly flagged concerns, conducting its own review of the emerging safety data and supporting the recall based on findings of increased harm.

Sickle cell patients who experience complications, such as organ damage, swelling, and intensified pain, are now urged to seek medical attention and discuss alternative treatment options with their doctors.
The Oxbryta recall has sparked growing frustration among patients and families, particularly in vulnerable regions like Sub-Saharan Africa, where sickle cell disease is prevalent and treatment options remain limited.
Legal and medical investigations are underway to determine whether Pfizer and its predecessor, Global Blood Therapeutics (GBT), adequately disclosed these risks and followed proper safety protocols.
Vaso-occlusive crises (VOCs) are a severe and painful complication of sickle cell disease (SCD), occurring when misshapen red blood cells block blood flow through small blood vessels.
In patients with SCD, red blood cells become rigid and sickle-shaped, losing their flexibility and ability to carry oxygen efficiently.
These deformed cells can clump together, obstructing blood vessels and depriving tissues and organs of vital oxygen, a condition known as ischemia.
The resulting lack of oxygen triggers episodes of intense pain, which can last for hours or days and may cause significant organ damage over time.
VOCs are one of the most common and debilitating complications of sickle cell disease, requiring immediate medical attention to manage pain and restore blood flow.
Repeated VOC episodes can lead to long-term damage to organs such as the liver, kidneys, and heart, as well as an increased risk of stroke.
Factors like dehydration, infection, stress, and extreme temperatures can trigger VOCs, although they can also occur spontaneously.
Treatments typically include pain management, hydration, and oxygen therapy, while severe cases may require blood transfusions to improve oxygen delivery and reduce further blockages.
Symptoms of Vaso-Occlusive Crises (VOCs):
VOCs are a serious, life-altering complication that requires prompt diagnosis and intervention to prevent worsening symptoms and long-term health impacts.
In addition to vaso-occlusive crises (VOCs), Oxbryta (voxelotor) has been associated with several other serious health complications that have raised concerns about its safety.
Emerging clinical data and real-world findings have linked the drug to a range of adverse effects, many of which further burden patients already managing the challenges of sickle cell disease.

Other potential health complications of Oxbryta include:
These complications underscore the risks that led to Oxbryta’s recall, as its use not only failed to improve some patients’ conditions but also introduced new, serious health concerns.
For individuals who experienced these side effects, ongoing medical care and monitoring are critical to address the drug’s impact on their overall health.
Oxbryta Lawsuits may claim that Pfizer failed to adequately warn patients taking Oxbryta of the serious health risks and complications associated with this sickle cell disease medication.
If Pfizer failed to adequately warn about Oxbryta’s risks and health complications, the company could be liable to pay compensation to individuals who took Oxbryta and suffered health issues.

If you or a loved one took Oxbryta and suffered from vaso-occlusive crises (VOCs), organ failure, or other health problems, you may be eligible to file an Oxbryta Lawsuit.
Contact TorHoerman Law today for a free consultation.
Use the chat feature on this page to find out if you qualify for the Oxbryta Lawsuit instantly.
Lawyers will help clients through the entire legal process, including the preliminary steps of gathering evidence to support their claims and assessing damages to seek compensation that reflects the pain and suffering of the client.
Building a strong case requires gathering detailed and well-documented evidence to demonstrate the link between the drug and the severe health complications experienced.
Evidence helps establish liability and ensures that the physical, emotional, and financial impacts of Oxbryta are accurately represented.
By compiling medical records, personal documentation, and expert opinions, affected individuals can build a comprehensive claim for compensation.

Evidence in Oxbryta Recall Lawsuits may include:
When pursuing an Oxbryta Lawsuit, understanding the types of damages you may be eligible to recover is essential.
Damages refer to the compensation sought to address the physical, emotional, and financial losses caused by the drug’s severe side effects.
By identifying these losses, affected individuals can build a compelling case for the full extent of the harm they have endured.

Potential damages in Oxbryta Lawsuits may include:
Oxbryta originally offered patients with sickle cell disease (SCD) a promising treatment designed to reduce red blood cell sickling and improve oxygen delivery throughout the body.
Approved through the FDA’s accelerated approval program, it was positioned as a breakthrough therapy for managing chronic anemia and reducing painful vaso-occlusive crises (VOCs).
However, emerging safety data revealed that many patients experienced severe complications, including worsening pain, organ damage, and an increased risk of fatalities.
These findings ultimately led to the drug’s recall, leaving patients and families searching for safer, more effective alternatives to manage the debilitating effects of SCD.
For patients taking Oxbryta who suffered severe complications, legal action may be a pathway to justice and compensation.

If you or a loved one took Oxbryta and subsequently suffered from vaso-occlusive crises (VOCs), organ failure, or other serious health complications, you may be eligible to file an Oxbryta Lawsuit.
Contact TorHoerman Law today for a free consultation.
Use the chat feature on this page to find out if you’re eligible to file an Oxbryta Lawsuit instantly.
Oxbryta (voxelotor) was a prescription medication approved by the FDA in 2019 as a treatment for sickle cell anemia, a genetic blood disorder characterized by the production of abnormal hemoglobin, causing red blood cells to become sickle-shaped.
These misshapen cells can block blood vessels, leading to chronic pain, organ damage, and painful episodes known as vaso-occlusive crises (VOCs).
Oxbryta was intended to stabilize hemoglobin, improve oxygen delivery, and reduce the risk of these complications, offering hope to patients living with this hereditary blood disorder.
However, recent safety reviews and findings from ongoing clinical trials revealed that Oxbryta did not perform as expected for many patients, leading to an increased incidence of fatal events and other severe complications compared to the placebo group.
As a result, Pfizer announced a global recall of the medication, and healthcare professionals were advised to stop prescribing Oxbryta and discuss alternative options with their patients.
Oxbryta was recalled in September 2024 after emerging safety data raised concerns about its overall risks and efficacy.
Post-marketing studies and active clinical trials revealed that patients taking Oxbryta experienced an increased rate of fatal events and severe complications, such as intensified painful episodes and organ damage, compared to those in the placebo group.
For many affected patients, the drug not only failed to reduce their symptoms but also contributed to extreme pain and worsened health outcomes, prompting healthcare professionals to reevaluate its use.
The recall was further supported by regulatory agencies, including the FDA, which emphasized that the medication no longer met the criteria for FDA approval due to its risks outweighing its benefits.
This decision underscores the importance of thorough, long-term testing for any new treatment for sickle cell disease, particularly for vulnerable populations living with this genetic blood disorder characterized by severe health challenges.
Following Pfizer’s announcement to stop prescribing Oxbryta, healthcare professionals are encouraged to prioritize patient safety by reviewing treatment plans for those affected.
Patients currently taking Oxbryta should immediately consult their doctors to discuss alternative therapies for managing sickle cell anemia and its associated symptoms, such as chronic pain and painful episodes.
Healthcare providers should carefully monitor affected patients for lingering complications related to Oxbryta and provide necessary support for symptom management and recovery.
Patients are also advised to document their health issues and consult legal professionals to determine eligibility for compensation, particularly if they experienced worsened symptoms, hospitalization, or severe outcomes such as fatal events.
By working together, patients and healthcare providers can transition to safer and more effective treatments while addressing the impacts of Oxbryta use.
For individuals who experienced severe complications or worsened health after taking Oxbryta, legal investigations are underway to hold responsible parties accountable.
Affected individuals may determine eligibility to file a claim by consulting with legal professionals, who can evaluate the connection between their symptoms and the medication.
Key issues under investigation include the lack of clear warnings about potential risks, such as increased painful episodes, organ damage, and the occurrence of fatal events.
Patients and families who relied on Oxbryta as a promising treatment for sickle cell disease may be entitled to compensation for medical expenses, lost wages, and the emotional toll of living with this hereditary blood disorder.
It is critical for affected individuals to gather medical records, document their experiences, and seek legal guidance to understand their options and advocate for justice following this recall.
Yes.
There is currently an active lawsuit Oxbryta investigation in the United States, with multiple personal injury claims being prepared for potential filing in federal court.
These claims center on allegations that Oxbryta caused serious complications and that its risks were not adequately disclosed to patients or health care providers.
The litigation follows the drug’s market withdrawal, which occurred after postmarketing clinical trials and further assessment revealed safety concerns, including higher rates of vaso-occlusive crises and other severe adverse events in certain patient groups.
Attorneys anticipate that many of these cases could be consolidated into multidistrict litigation (MDL) if enough Oxbryta prescriptions are linked to similar injuries across multiple states.
This structure would allow pretrial proceedings, discovery, and expert testimony to be managed in a coordinated way while still preserving each plaintiff’s right to an individual outcome.
The first Oxbryta lawsuits are expected to set important precedents for settlement negotiations, trial strategy, and damage valuations.
Evidence in these cases will likely include data from the original Oxbryta trial, follow-up studies, internal communications between pharmaceutical companies involved in development and marketing, and guidance from agencies such as the National Institute for Health and Care Excellence.
Plaintiffs may seek damages for medical costs, lost income, pain and suffering, and wrongful death.
While no official trial date has been set, legal experts believe the litigation will focus heavily on whether the overall benefit of Oxbryta ever outweighed the risks presented by emerging safety data.
Anyone who believes they were harmed by Oxbryta should speak with an attorney experienced in defective drug litigation to discuss joining the ongoing case and protecting their right to compensation.
Owner & Attorney - TorHoerman Law
Here, at TorHoerman Law, we’re committed to helping victims get the justice they deserve.
Since 2009, we have successfully collected over $4 Billion in verdicts and settlements on behalf of injured individuals.
Would you like our help?
At TorHoerman Law, we believe that if we continue to focus on the people that we represent, and continue to be true to the people that we are – justice will always be served.
Do you believe you’re entitled to compensation?
Use our Instant Case Evaluator to find out in as little as 60 seconds!
In this case, we obtained a verdict of $495 Million for our client’s child who was diagnosed with Necrotizing Enterocolitis after consuming baby formula manufactured by Abbott Laboratories.
In this case, we were able to successfully recover $20 Million for our client after they suffered a Toxic Tort Injury due to chemical exposure.
In this case, we were able to successfully recover $103.8 Million for our client after they suffered a COX-2 Inhibitors Injury.
In this case, we were able to successfully recover $4 Million for our client after they suffered a Traumatic Brain Injury while at daycare.
In this case, we were able to successfully recover $2.8 Million for our client after they suffered an injury due to a Defective Heart Device.
Here, at TorHoerman Law, we’re committed to helping victims get the justice they deserve.
Since 2009, we have successfully collected over $4 Billion in verdicts and settlements on behalf of injured individuals.
Would you like our help?
They helped my elderly uncle receive compensation for the loss of his wife who was administered a dangerous drug. He consulted with this firm because of my personal recommendation and was very pleased with the compassion, attention to detail and response he received. Definitely recommend this firm for their 5 star service.
When I wanted to join the Xarelto class action lawsuit, I chose TorrHoerman Law from a search of a dozen or so law firm websites. I was impressed with the clarity of the information they presented. I gave them a call, and was again impressed, this time with the quality of our interactions.
TorHoerman Law is an awesome firm to represent anyone that has been involved in a case that someone has stated that it's too difficult to win. The entire firm makes you feel like you’re part of the family, Tor, Eric, Jake, Kristie, Chad, Tyler, Kathy and Steven are the best at what they do.
TorHorman Law is awesome
I can’t say enough how grateful I was to have TorHoerman Law help with my case. Jacob Plattenberger is very knowledgeable and an amazing lawyer. Jillian Pileczka was so patient and kind, helping me with questions that would come up. Even making sure my special needs were taken care of for meetings.
TorHoerman Law fights for justice with their hardworking and dedicated staff. Not only do they help their clients achieve positive outcomes, but they are also generous and important pillars of the community with their outreach and local support. Thank you THL!
Hands down one of the greatest group of people I had the pleasure of dealing with!
A very kind and professional staff.
Very positive experience. Would recommend them to anyone.
A very respectful firm.